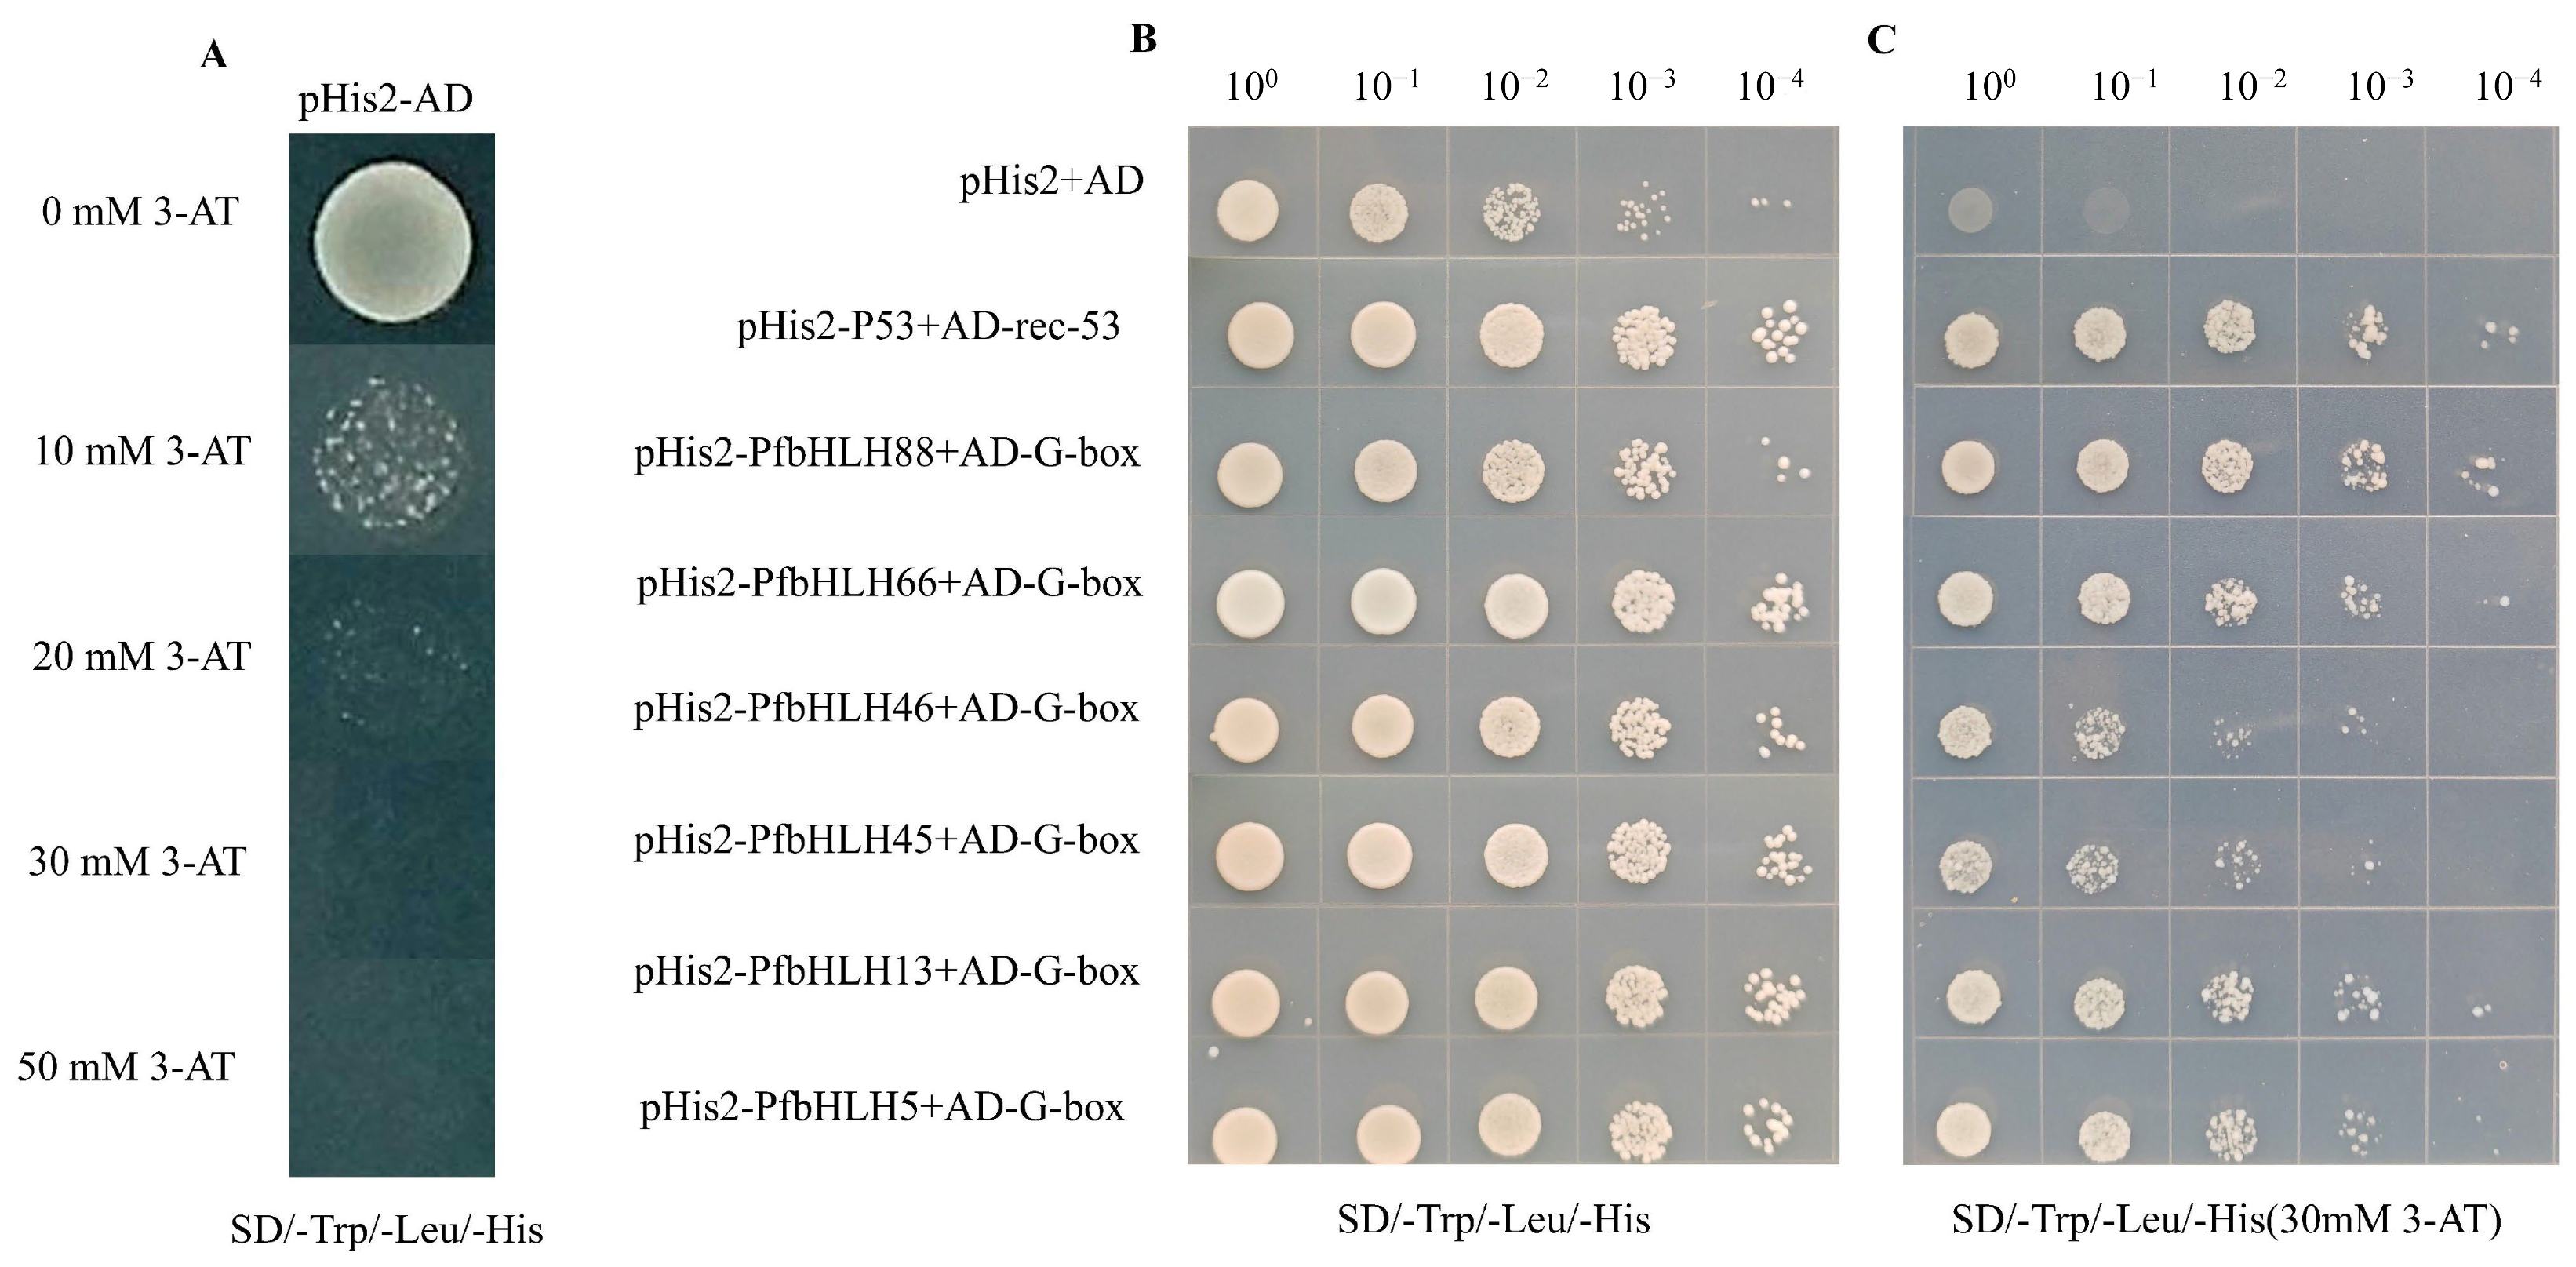
Ijms 25 13717 g010

Genome-Wide Characterization and Analysis of the bHLH Gene Family in Perilla frutescens
Abstract
1. Introduction
2. Results
2.1. Chromosomal Distribution and Characterization of PfbHLHs
2.2. Gene Structure and Conserved Motif Analysis of PfbHLH Genes
2.3. Multiple Sequence Alignment and Phylogenetic Analysis of PfbHLHs
2.4. Cis-Acting Element Analysis
2.5. Gene Duplication Events and Synteny Analysis of PfbHLHs
2.6. Expression Analysis of the PfbHLH Gene Family in Different Tissues
2.7. Expression Analysis of PfbHLHs Under MeJA Treatment
2.8. Subcellular Localization Analysis and Verification of Transcriptional Activation
2.9. Yeast One-Hybrid Analysis
3. Discussion
4. Materials and Methods
4.1. Identification of PfbHLH Genes
4.2. Chromosomal Distribution, Gene Duplication, and Synteny
4.3. Multiple Sequence Alignment and Phylogenetic Analysis
4.4. Gene Structure and Conserved Motif
4.5. Expression Pattern Analysis of the PfbHLH Gene Family in Different Tissues
4.6. Plant Materials and MeJA Treatment
4.7. RNA Isolation and qRT-PCR Validation
4.8. Subcellular Localization and Transcriptional Activation Analysis of PfbHLHs
4.9. Yeast One-Hybrid (Y1H) Assays
5. Conclusions
Supplementary Materials
Author Contributions
Funding
Institutional Review Board Statement
Informed Consent Statement
Data Availability Statement
Conflicts of Interest
References
- Pires, N.; Dolan, L. Origin and diversification of basic-helix-loop-helix proteins in plants. Mol. Biol. Evol. 2010, 27, 862–874. [Google Scholar] [CrossRef] [PubMed]
- Heim, M.A.; Jakoby, M.; Werber, M.; Martin, C.; Weisshaar, B.; Bailey, P.C. The Basic Helix-Loop-Helix Transcription Factor Family in Plants: A Genome-Wide Study of Protein Structure and Functional Diversity. Mol. Biol. Evol. 2003, 20, 735–747. [Google Scholar] [CrossRef]
- Murre, C.; McCaw, P.S.; Baltimore, D. A new DNA binding and dimerization motif in immunoglobulin enhancer binding, daughterless, MyoD, and myc proteins. Cell 1989, 56, 777–783. [Google Scholar] [CrossRef]
- Ludwig, S.R.; Habera, L.F.; Dellaporta, S.L.; Wessler, S.R. Lc, a Member of the Maize R Gene Family Responsible for Tissue-Specific Anthocyanin Production, Encodes a Protein Similar to Transcriptional Activators and Contains the Myc-Homology Region. Proc. Natl. Acad. Sci. USA 1989, 86, 7092–7096. [Google Scholar] [CrossRef] [PubMed]
- Bailey, P.C.; Martin, C.; Toledo-Ortiz, G.; Quail, P.H.; Huq, E.; Heim, M.A.; Jakoby, M.; Werber, M.; Weisshaar, B. Update on the Basic Helix-Loop-Helix Transcription Factor Gene Family in Arabidopsis thaliana. Plant Cell 2003, 15, 2497–2502. [Google Scholar] [CrossRef] [PubMed]
- Li, X.; Duan, X.; Jiang, H.; Sun, Y.; Tang, Y.; Yuan, Z.; Guo, J.; Liang, W.; Chen, L.; Yin, J.; et al. Genome-Wide Analysis of Basic/Helix-Loop-Helix Transcription Factor Family in Rice and Arabidopsis. Plant Physiol. 2006, 141, 1167–1184. [Google Scholar] [CrossRef]
- Huang, Y.; Xing, X.; Jin, J.; Tang, Y.; Ding, L.; Song, A.; Chen, S.; Chen, F.; Jiang, J.; Fang, W. CmbHLH110, a novel bHLH transcription factor, accelerates flowering in chrysanthemum. Hortic. Plant J. 2024, 10, 1437–1448. [Google Scholar] [CrossRef]
- Xiang, L.; He, P.; Shu, G.; Yuan, M.; Wen, M.; Lan, X.; Liao, Z.; Tang, Y. AabHLH112, a bHLH transcription factor, positively regulates sesquiterpenes biosynthesis in Artemisia annua. Front. Plant Sci. 2022, 13, 973591. [Google Scholar] [CrossRef]
- Zhu, J.-H.; Xia, D.-N.; Xu, J.; Guo, D.; Li, H.-L.; Wang, Y.; Mei, W.-L.; Peng, S.-Q. Identification of the bHLH gene family in Dracaena cambodiana reveals candidate genes involved in flavonoid biosynthesis. Ind. Crops Prod. 2020, 150, 112407. [Google Scholar] [CrossRef]
- Gao, Y.; Liu, J.; Chen, Y.; Tang, H.; Wang, Y.; He, Y.; Ou, Y.; Sun, X.; Wang, S.; Yao, Y. Tomato SlAN11 regulates flavonoid biosynthesis and seed dormancy by interaction with bHLH proteins but not with MYB proteins. Hortic. Res. 2018, 5, 27. [Google Scholar] [CrossRef] [PubMed]
- Xie, X.-B.; Li, S.; Zhang, R.-F.; Zhao, J.; Chen, Y.-C.; Zhao, Q.; Yao, Y.-X.; You, C.-X.; Zhang, X.-S.; Hao, Y.-J. The bHLH transcription factor MdbHLH3 promotes anthocyanin accumulation and fruit colouration in response to low temperature in apples. Plant Cell Environ. 2012, 35, 1884–1897. [Google Scholar] [CrossRef] [PubMed]
- Song, Y.; Li, S.; Sui, Y.; Zheng, H.; Han, G.; Sun, X.; Yang, W.; Wang, H.; Zhuang, K.; Kong, F.; et al. SbbHLH85, a bHLH member, modulates resilience to salt stress by regulating root hair growth in sorghum. Theor. Appl. Genet. 2022, 135, 201–216. [Google Scholar] [CrossRef]
- Li, C.; Yan, C.; Sun, Q.; Wang, J.; Yuan, C.; Mou, Y.; Shan, S.; Zhao, X. The bHLH transcription factor AhbHLH112 improves the drought tolerance of peanut. BMC Plant Biol. 2021, 21, 540. [Google Scholar] [CrossRef]
- Zhou, M.; Memelink, J. Jasmonate-responsive transcription factors regulating plant secondary metabolism. Biotechnol. Adv. 2016, 34, 441–449. [Google Scholar] [CrossRef]
- Goossens, J.; Mertens, J.; Goossens, A. Role and functioning of bHLH transcription factors in jasmonate signalling. J. Exp. Bot. 2017, 68, 1333–1347. [Google Scholar] [CrossRef]
- Liu, S.; Wang, Y.; Shi, M.; Maoz, I.; Gao, X.; Sun, M.; Yuan, T.; Li, K.; Zhou, W.; Guo, X.; et al. SmbHLH60 and SmMYC2 antagonistically regulate phenolic acids and anthocyanins biosynthesis in Salvia miltiorrhiza. J. Adv. Res. 2022, 42, 205–219. [Google Scholar] [CrossRef] [PubMed]
- Xing, B.; Liang, L.; Liu, L.; Hou, Z.; Yang, D.; Yan, K.; Zhang, X.; Liang, Z. Overexpression of SmbHLH148 induced biosynthesis of tanshinones as well as phenolic acids in Salvia miltiorrhiza hairy roots. Plant Cell Rep. 2018, 37, 1681–1692. [Google Scholar] [CrossRef]
- Yang, S.-M.; Chu, H.-Y.; Wang, Y.-X.; Guo, B.-L.; An, T.-Y.; Shen, Q.; Yang, S.-M.; Chu, H.-Y.; Wang, Y.-X.; Guo, B.-L.; et al. Analysis of Monoterpene Biosynthesis and Functional TPSs of Perilla Frutescens Based on Transcriptome and Metabolome. Medicinal Plant Biology 2024, 3, e017. [Google Scholar] [CrossRef]
- Wu, X.; Dong, S.; Chen, H.; Guo, M.; Sun, Z.; Luo, H. Perilla frutescens: A traditional medicine and food homologous plant. Chin. Herb. Med. 2023, 15, 369–375. [Google Scholar] [CrossRef] [PubMed]
- Zhang, J.; Cui, X.; Zhang, M.; Bai, B.; Yang, Y.; Fan, S. The antibacterial mechanism of perilla rosmarinic acid. Biotechnol. Appl. Biochem. 2022, 69, 1757–1764. [Google Scholar] [CrossRef] [PubMed]
- Chen, J.; Zhao, Y.; Cheng, J.; Wang, H.; Pan, S.; Liu, Y. The Antiviral Potential of Perilla frutescens: Advances and Perspectives. Molecules 2024, 29, 3328. [Google Scholar] [CrossRef] [PubMed]
- Nguyen, T.K.L.; Oh, M.-M. Physiological and biochemical responses of green and red perilla to LED-based light. J. Sci. Food Agric. 2021, 101, 240–252. [Google Scholar] [CrossRef]
- Cheng, Y.; Hong, X.; Zhang, L.; Yang, W.; Zeng, Y.; Hou, Z.; Yang, Z.; Yang, D.; Cheng, Y.; Hong, X.; et al. Transcriptomic Analysis Provides Insight into the Regulation Mechanism of Silver Ions (Ag+) and Jasmonic Acid Methyl Ester (MeJA) on Secondary Metabolism in the Hairy Roots of Salvia Miltiorrhiza Bunge (Lamiaceae). Med. Plant Biol. 2023, 2, 3. [Google Scholar] [CrossRef]
- Zhang, Y.; Shen, Q.; Leng, L.; Zhang, D.; Chen, S.; Shi, Y.; Ning, Z.; Chen, S. Incipient diploidization of the medicinal plant Perilla within 10,000 years. Nat. Commun. 2021, 12, 5508. [Google Scholar] [CrossRef] [PubMed]
- Zhang, J.; Lv, H.; Liu, W.; Ji, A.; Zhang, X.; Song, J.; Luo, H.; Chen, S. bHLH transcription factor SmbHLH92 negatively regulates biosynthesis of phenolic acids and tanshinones in Salvia miltiorrhiza. Chin. Herb. Med. 2020, 12, 237–246. [Google Scholar] [CrossRef]
- Du, T.; Niu, J.; Su, J.; Li, S.; Guo, X.; Li, L.; Cao, X.; Kang, J. SmbHLH37 Functions Antagonistically with SmMYC2 in Regulating Jasmonate-Mediated Biosynthesis of Phenolic Acids in Salvia miltiorrhiza. Front. Plant Sci. 2018, 9, 1720. [Google Scholar] [CrossRef] [PubMed]
- Dong, Y.; Wang, C.; Han, X.; Tang, S.; Liu, S.; Xia, X.; Yin, W. A novel bHLH transcription factor PebHLH35 from Populus euphratica confers drought tolerance through regulating stomatal development, photosynthesis and growth in Arabidopsis. Biochem. Biophys. Res. Commun. 2014, 450, 453–458. [Google Scholar] [CrossRef]
- Yu, C.; Yan, M.; Dong, H.; Luo, J.; Ke, Y.; Guo, A.; Chen, Y.; Zhang, J.; Huang, X. Maize bHLH55 functions positively in salt tolerance through modulation of AsA biosynthesis by directly regulating GDP-mannose pathway genes. Plant Sci. Int. J. Exp. Plant Biol. 2021, 302, 110676. [Google Scholar] [CrossRef]
- Li, J.; Wang, T.; Han, J.; Ren, Z. Genome-wide identification and characterization of cucumber bHLH family genes and the functional characterization of CsbHLH041 in NaCl and ABA tolerance in Arabidopsis and cucumber. BMC Plant Biol. 2020, 20, 272. [Google Scholar] [CrossRef]
- Li, L.; Gao, W.; Peng, Q.; Zhou, B.; Kong, Q.; Ying, Y.; Shou, H. Two soybean bHLH factors regulate response to iron deficiency. J. Integr. Plant Biol. 2018, 60, 608–622. [Google Scholar] [CrossRef]
- Xu, W.; Jiao, Y.; Li, R.; Zhang, N.; Xiao, D.; Ding, X.; Wang, Z. Chinese Wild-Growing Vitis Amurensis ICE1 and ICE2 Encode MYC-Type bHLH Transcription Activators That Regulate Cold Tolerance in Arabidopsis. PLoS ONE 2014, 9, e102303. [Google Scholar] [CrossRef] [PubMed]
- Zhang, C.; Xing, B.; Yang, D.; Ren, M.; Guo, H.; Yang, S.; Liang, Z. SmbHLH3 acts as a transcription repressor for both phenolic acids and tanshinone biosynthesis in Salvia miltiorrhiza hairy roots. Phytochemistry 2020, 169, 112183. [Google Scholar] [CrossRef]
- Xing, B. Overexpression of SmbHLH10 enhances tanshinones biosynthesis in Salvia miltiorrhiza hairy roots. Plant Sci. 2018, 276, 229–238. [Google Scholar] [CrossRef]
- Peng, J.-J.; Wu, Y.-C.; Wang, S.-Q.; Niu, J.-F.; Cao, X.-Y. SmbHLH53 is relevant to jasmonate signaling and plays dual roles in regulating the genes for enzymes in the pathway for salvianolic acid B biosynthesis in Salvia miltiorrhiza. Gene 2020, 756, 144920. [Google Scholar] [CrossRef]
- Zuo, Z.-F.; Lee, H.-Y.; Kang, H.-G. Basic Helix-Loop-Helix Transcription Factors: Regulators for Plant Growth Development and Abiotic Stress Responses. Int. J. Mol. Sci. 2023, 24, 1419. [Google Scholar] [CrossRef]
- Feller, A.; Machemer, K.; Braun, E.L.; Grotewold, E. Evolutionary and comparative analysis of MYB and bHLH plant transcription factors. Plant J. Cell Mol. Biol. 2011, 66, 94–116. [Google Scholar] [CrossRef] [PubMed]
- Zhang, X.; Luo, H.; Xu, Z.; Zhu, Y.; Ji, A.; Song, J.; Chen, S. Genome-wide characterisation and analysis of bHLH transcription factors related to tanshinone biosynthesis in Salvia miltiorrhiza. Sci. Rep. 2015, 5, 11244. [Google Scholar] [CrossRef] [PubMed]
- Xu, J.; Xu, H.; Zhao, H.; Liu, H.; Xu, L.; Liang, Z. Genome-wide investigation of bHLH genes and expression analysis under salt and hormonal treatments in Andrographis paniculata. Ind. Crops Prod. 2022, 183, 114928. [Google Scholar] [CrossRef]
- Chu, Y.; Xiao, S.; Su, H.; Liao, B.; Zhang, J.; Xu, J.; Chen, S. Genome-wide characterization and analysis of bHLH transcription factors in Panax ginseng. Acta Pharm. Sin. B 2018, 8, 666–677. [Google Scholar] [CrossRef] [PubMed]
- Fonseca, S.; Fernández-Calvo, P.; Fernández, G.M.; Díez-Díaz, M.; Gimenez-Ibanez, S.; López-Vidriero, I.; Godoy, M.; Fernández-Barbero, G.; Van Leene, J.; De Jaeger, G.; et al. bHLH003, bHLH013 and bHLH017 Are New Targets of JAZ Repressors Negatively Regulating JA Responses. PLoS ONE 2014, 9, e86182. [Google Scholar] [CrossRef] [PubMed]
- Song, H.; Geng, Q.; Wu, X.; Hu, M.; Ye, M.; Yu, X.; Chen, Y.; Xu, J.; Jiang, L.; Cao, S. The transcription factor MYC1 interacts with FIT to negatively regulate iron homeostasis in Arabidopsis thaliana. Plant J. 2023, 114, 193–208. [Google Scholar] [CrossRef] [PubMed]
- Panchy, N.; Lehti-Shiu, M.; Shiu, S.-H. Evolution of Gene Duplication in Plants. Plant Physiol. 2016, 171, 2294–2316. [Google Scholar] [CrossRef]
- Xu, G.; Guo, C.; Shan, H.; Kong, H. Divergence of duplicate genes in exon–intron structure. Proc. Natl. Acad. Sci. USA 2012, 109, 1187–1192. [Google Scholar] [CrossRef]
- Wittkopp, P.J.; Kalay, G. Cis-regulatory elements: Molecular mechanisms and evolutionary processes underlying divergence. Nat. Rev. Genet. 2011, 13, 59–69. [Google Scholar] [CrossRef]
- Zhou, Z.; Wang, J.; Yu, Q.; Lan, H. Promoter activity and transcriptome analyses decipher functions of CgbHLH001 gene (Chenopodium glaucum L.) in response to abiotic stress. BMC Plant Biol. 2023, 23, 116. [Google Scholar] [CrossRef]
- Zhu, L.; Zhao, M.; Chen, M.; Li, L.; Jiang, Y.; Liu, S.; Jiang, Y.; Wang, K.; Wang, Y.; Sun, C.; et al. The bHLH gene family and its response to saline stress in Jilin ginseng, Panax ginseng C.A. Meyer. Mol. Genet. Genom. 2020, 295, 877–890. [Google Scholar] [CrossRef]
- Inoue, M.; Horimoto, K. Relationship between regulatory pattern of gene expression level and gene function. PLoS ONE 2017, 12, e0177430. [Google Scholar] [CrossRef] [PubMed]
- Zhu, Z.; Liang, H.; Chen, G.; Li, F.; Wang, Y.; Liao, C.; Hu, Z. The bHLH transcription factor SlPRE2 regulates tomato fruit development and modulates plant response to gibberellin. Plant Cell Rep. 2019, 38, 1053–1064. [Google Scholar] [CrossRef]
- Tan, C.; Qiao, H.; Ma, M.; Wang, X.; Tian, Y.; Bai, S.; Hasi, A. Genome-Wide Identification and Characterization of Melon bHLH Transcription Factors in Regulation of Fruit Development. Plants 2021, 10, 2721. [Google Scholar] [CrossRef] [PubMed]
- Mistry, J.; Chuguransky, S.; Williams, L.; Qureshi, M.; Salazar, G.A.; Sonnhammer, E.L.L.; Tosatto, S.C.E.; Paladin, L.; Raj, S.; Richardson, L.J.; et al. Pfam: The protein families database in 2021. Nucleic Acids Res. 2021, 49, D412–D419. [Google Scholar] [CrossRef]
- Lu, S.; Wang, J.; Chitsaz, F.; Derbyshire, M.K.; Geer, R.C.; Gonzales, N.R.; Gwadz, M.; Hurwitz, D.I.; Marchler, G.H.; Song, J.S.; et al. CDD/SPARCLE: The conserved domain database in 2020. Nucleic Acids Res. 2020, 48, D265–D268. [Google Scholar] [CrossRef]
- Chen, C.; Chen, H.; Zhang, Y.; Thomas, H.R.; Frank, M.H.; He, Y.; Xia, R. TBtools: An Integrative Toolkit Developed for Interactive Analyses of Big Biological Data. Mol. Plant 2020, 13, 1194–1202. [Google Scholar] [CrossRef] [PubMed]
- Lescot, M.; Déhais, P.; Thijs, G.; Marchal, K.; Moreau, Y.; Van de Peer, Y.; Rouzé, P.; Rombauts, S. PlantCARE, a database of plant cis-acting regulatory elements and a portal to tools for in silico analysis of promoter sequences. Nucleic Acids Res. 2002, 30, 325–327. [Google Scholar] [CrossRef] [PubMed]
- Crooks, G.E.; Hon, G.; Chandonia, J.-M.; Brenner, S.E. WebLogo: A sequence logo generator. Genome Res. 2004, 14, 1188–1190. [Google Scholar] [CrossRef] [PubMed]
- Livak, K.J.; Schmittgen, T.D. Analysis of Relative Gene Expression Data Using Real-Time Quantitative PCR and the 2−ΔΔCT Method. Methods 2001, 25, 402–408. [Google Scholar] [CrossRef]

Disclaimer/Publisher’s Note: The statements, opinions and data contained in all publications are solely those of the individual author(s) and contributor(s) and not of MDPI and/or the editor(s). MDPI and/or the editor(s) disclaim responsibility for any injury to people or property resulting from any ideas, methods, instructions or products referred to in the content. |
© 2024 by the authors. Licensee MDPI, Basel, Switzerland. This article is an open access article distributed under the terms and conditions of the Creative Commons Attribution (CC BY) license (https://creativecommons.org/licenses/by/4.0/).
Share and Cite
Chen, J.; Xu, J.; Wang, P.; Wang, Y.; Wang, Y.; Lian, J.; Yan, Y.; Cheng, L.; Wang, Y.; Di, P. Genome-Wide Characterization and Analysis of the bHLH Gene Family in Perilla frutescens. Int. J. Mol. Sci. 2024, 25, 13717. https://doi.org/10.3390/ijms252413717
Chen J, Xu J, Wang P, Wang Y, Wang Y, Lian J, Yan Y, Cheng L, Wang Y, Di P. Genome-Wide Characterization and Analysis of the bHLH Gene Family in Perilla frutescens. International Journal of Molecular Sciences. 2024; 25(24):13717. https://doi.org/10.3390/ijms252413717
Chicago/Turabian StyleChen, Jiankang, Jiayi Xu, Ping Wang, Yihan Wang, Yumeng Wang, Junmei Lian, Yan Yan, Lin Cheng, Yingping Wang, and Peng Di. 2024. "Genome-Wide Characterization and Analysis of the bHLH Gene Family in Perilla frutescens" International Journal of Molecular Sciences 25, no. 24: 13717. https://doi.org/10.3390/ijms252413717
APA StyleChen, J., Xu, J., Wang, P., Wang, Y., Wang, Y., Lian, J., Yan, Y., Cheng, L., Wang, Y., & Di, P. (2024). Genome-Wide Characterization and Analysis of the bHLH Gene Family in Perilla frutescens. International Journal of Molecular Sciences, 25(24), 13717. https://doi.org/10.3390/ijms252413717

